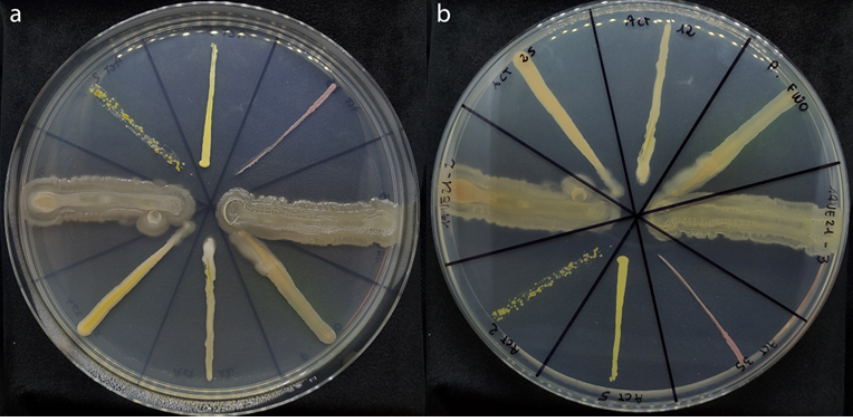

Di Luca Nerva e Walter Chitarra
Clima sempre più caldo e siccità mettono sotto pressione la viticoltura europea, riducendo rese e salute delle piante. Il progetto Micro4Life punta su un alleato invisibile: il microbioma della vite, una comunità di microrganismi che vive in simbiosi con la pianta. I ricercatori del CREA hanno selezionato batteri e funghi benefici, combinandoli in consorzi capaci di aumentare la resistenza alla carenza d’acqua. I test, dal laboratorio al vigneto, mostrano viti più efficienti nell’uso dell’acqua e più rapide nel recupero dallo stress. Benefici anche per il suolo, con maggiore fertilità e attività biologica. Una strategia promettente per una viticoltura più sostenibile e resiliente ai cambiamenti climatici.
La viticoltura europea sta affrontando stagioni sempre più calde e periodi di siccità più frequenti. Questo significa stress per le piante, calo di produzione e maggiore vulnerabilità a malattie e squilibri fisiologici. Ma una parte della soluzione potrebbe trovarsi proprio sotto i nostri piedi: nel suolo e nei microrganismi che vivono insieme alla vite. Il progetto Micro4Life ha esplorato proprio questo mondo invisibile, cercando di capire come i microrganismi associati alla vite possano diventare alleati per rendere i vigneti più resilienti ai cambiamenti climatici.
La vite non è mai sola
Quando osserviamo una pianta di vite tendiamo a considerarla un organismo autonomo. In realtà ogni pianta vive in stretta relazione con una vasta comunità di microrganismi (batteri, funghi e virus) che colonizzano radici, foglie e suolo. Insieme formano quello che viene definito un “olobionte”: un sistema biologico integrato in cui pianta e microrganismi cooperano per adattarsi all’ambiente e rispondere agli stress. Comprendere e valorizzare queste interazioni è stato uno degli obiettivi del progetto Micro4Life, che ha studiato il microbioma della vite per individuare microrganismi capaci di migliorare la capacità delle piante di affrontare condizioni ambientali difficili, in particolare la carenza d’acqua.
Dalla biodiversità microbica ai consorzi benefici
Il lavoro è iniziato con l’esplorazione della biodiversità microbica associata alla vite. I ricercatori hanno isolato numerosi microrganismi benefici direttamente da piante che crescono in ambienti difficili o soggetti a stress. Questi isolati sono stati identificati, caratterizzati e conservati nella ViMed Biomebank, una collezione di microrganismi endofiti e patogeni del CREA, disponibile per future applicazioni di ricerca.
Microrganismi endofiti
Si tratta di batteri e funghi che vivono all’interno dei tessuti vegetali – radici, fusti, foglie – senza causare danni alla pianta ospite, instaurando spesso una relazione simbiotica. Essi promuovono la crescita vegetale, migliorano l’assorbimento dei nutrienti e aumentano la resistenza a stress abiotici – siccità, salinità

Partendo da questa risorsa sono stati selezionati i ceppi più promettenti e combinati in consorzi microbici (in gergo tecnico SynCom, synthetic communities).
Gli esperimenti condotti su giovani barbatelle hanno mostrato risultati significativi: le piante, inoculate con alcuni consorzi microbici selezionati, hanno tollerato meglio la carenza d’acqua, raggiungendo livelli di stress severo più tardi e recuperando più rapidamente dopo la reidratazione, rispetto alle piante senza l’inoculo dei microrganismi.
Dal laboratorio al vigneto
Per verificare se questi effetti fossero replicabili anche in condizioni reali, uno dei consorzi microbici più promettenti è stato valutato anche in un vigneto commerciale di Nebbiolo. Le piante trattate hanno mostrato una maggiore efficienza fotosintetica e un miglior utilizzo dell’acqua, due parametri fondamentali per affrontare periodi di siccità. Parallelamente sono stati osservati effetti positivi anche sul suolo: aumento del carbonio disponibile, maggiore attività biologica e livelli più elevati di nutrienti come azoto e fosforo. Questi risultati suggeriscono che i consorzi microbici non agiscono solo sulla pianta, ma contribuiscono anche a migliorare la fertilità del suolo.

Le prospettive della ricerca
I risultati del progetto indicano che il microbioma della vite può rappresentare uno strumento concreto per una viticoltura più sostenibile. L’integrazione tra inoculi microbici e pratiche agronomiche conservative, come la riduzione delle lavorazioni del suolo, potrebbe rafforzare la resilienza dei vigneti e ridurre la dipendenza da input chimici. Le ricerche proseguono per comprendere più a fondo i meccanismi biologici che regolano queste interazioni e trasformare queste conoscenze in soluzioni applicabili su larga scala. In un contesto climatico sempre più incerto, valorizzare l’alleanza tra piante e microrganismi potrebbe diventare una delle chiavi per il futuro della viticoltura.
Micro4Life – Microbioma per una viticoltura resiliente
Finanziamento: Fondazione AGER (Agroalimentare e Ricerca)
Obiettivo: studiare e valorizzare i microrganismi associati alla vite per migliorare la resilienza delle piante agli stress ambientali e promuovere pratiche viticole più sostenibili.
Approccio: isolamento e caratterizzazione di microrganismi benefici, sviluppo di consorzi microbici (SynCom) e test in laboratorio e in vigneto.
Ricadute attese: riduzione dell’impatto degli stress climatici, miglioramento della fertilità del suolo e supporto a sistemi viticoli più sostenibili.

Ricercatore CREA Centro di ricerca Viticoltura ed Enologia
Studia l’interazione pianta-microrganismi sfruttando le biotecnologie e le metodiche molecolari più avanzate e innovative per identificare i tratti coinvolti nella resilienza agli stress ambientali. Lavora dal 2019 all’applicazione delle Tecnologie di Evoluzione Assistita (TEA) per migliorare la resilienza al cambiamento climatico della vite. Autore di oltre 50 pubblicazioni su riviste internazionali con impact factor e coinvolto in numerosi progetti di ricerca nazionali e internazionali.
#lafrase: Se c’è in me qualcosa che si può definire sentimento religioso, è proprio quella sconfinata ammirazione per la struttura del mondo nei limiti in cui la scienza ce la può rivelare (Albert Einstein)

Primo Ricercatore CREA Centro di ricerca Viticoltura ed Enologia
L’attività di ricerca è focalizzata sullo studio dell’interazione pianta-patogeno e le biotecnologie sostenibili per il loro controllo e per aumentare le difese della pianta anche a stress abiotici (es. stress idrico). E’ autore di oltre 50 lavori scientifici su riviste internazionali con IF. H-index: 20
#lafrase Lo scienziato nel suo laboratorio non è solo un tecnico, è anche un bambino davanti a fenomeni della natura che lo affascinano come un racconto di fate
(Marie Curie)